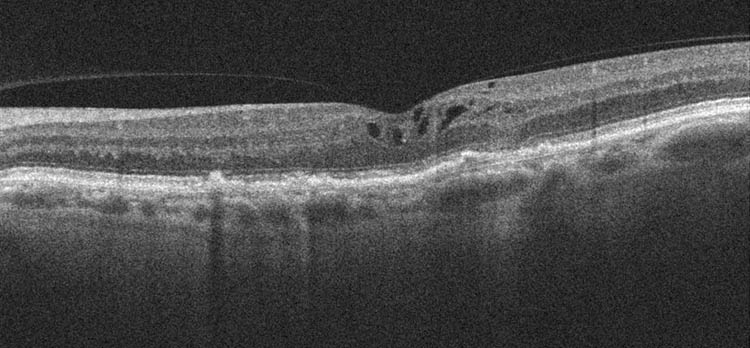
Intravitreale Injektion

La consonne occlusive injective uvulaire est un son consonantique existant dans certaines langues. Le symbole dans l'alphabet phonétique international est [ʛ].
Caractéristiques
Voici les caractéristiques de la consonne occlusive injective uvulaire voisée :
- Son mode d'articulation est occlusif, ce qui signifie qu'elle est produite en obstruant l’air du chenal vocal.
- Elle est injective, ce qui signifie qu'elle est accompagnée d'un flux glottal entrant ; elle ne nécessite donc pas d'air provenant des poumons.
- Son point d'articulation est uvulaire, ce qui signifie qu'elle est articulée avec le dos de la langue (la dorsal) contre ou près de la luette.
- Sa phonation est voisée, ce qui signifie que les cordes vocales vibrent lors de l’articulation.
- C'est une consonne orale, ce qui signifie que l'air ne s’échappe que par la bouche.
- C'est une consonne centrale, ce qui signifie qu’elle est produite en laissant l'air passer au-dessus du milieu de la langue, plutôt que par les côtés.
- Son mécanisme de courant d'air est ingressif glottal, ce qui signifie qu'elle est articulée grâce à un mouvement de l'air vers l'arrière produit par un abaissement de la glotte.
En français
Le français ne possède pas le [ʛ].
Dans les autres langues
- mam: [ʛa]; "feu"
Voir aussi
- Mode d'articulation
- Point d'articulation
- Portail de la linguistique